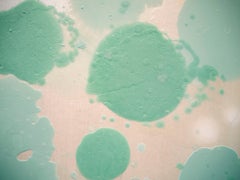
Katsumi Hayakawa, Distorting Soup, Mixed Media Painting on Wood Panel, 2019

On 1stDibs, you can find the most appropriate katsumi hayakawa for your needs in our varied inventory. There are many
Abstract and
Contemporary versions of these works for sale. When looking for the right katsumi hayakawa for your space, you can search on 1stDibs by color — popular works were created in bold and neutral palettes with elements of
brown,
gray,
black and
purple. Artworks like these of any era or style can make for thoughtful decor in any space, but a selection from our variety of those made in
mixed media,
paper and
acrylic paint can add an especially memorable touch. A large katsumi hayakawa can be an attractive addition to some spaces, while smaller examples are available — approximately spanning 18.9 high and 12.6 wide — and may be better suited to a more modest living area.
A katsumi hayakawa can differ in price owing to various characteristics — the average selling price for items in our inventory is $8,100, while the lowest priced sells for $4,000 and the highest can go for as much as $28,000.